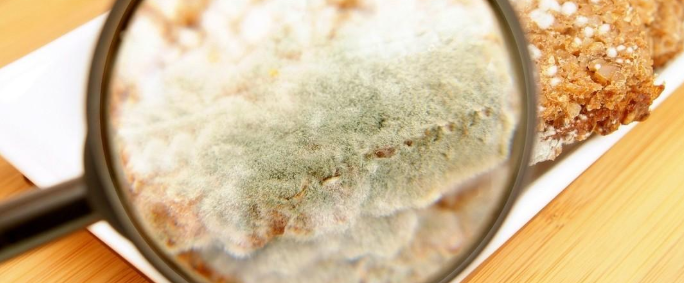

最佳回答
本文由作者推荐
详细内容
- 01
黄曲霉毒素常见于霉变的干果、坚果和谷物等食品中。黄曲霉素污染主要存在于发霉的玉米中。黄曲霉毒素及其产生菌在自然界中分布广泛,有些菌株产生不止一种类型的黄曲霉毒素,在黄曲霉中也有不产生任何类型黄曲霉毒素的菌株。黄曲霉毒素主要污染粮油及其制品,各种植物性与动物性食品也能被污染。

黄曲霉毒素常见于霉变的干果、坚果和谷物等食品中。黄曲霉素污染主要存在于发霉的玉米中。特别是淀粉含量高的食物里,淀粉在高温和潮湿的环境下会滋生导致肝癌的黄曲霉菌。我们常吃的大米、小米、豆类,尤其是在高温湿润的环境下,一旦霉变也会陷入它的魔爪。在湿热地区食品和饲料中出现黄曲霉毒素的机率最高。

1960年首次于英国伦敦郊区“火鸡X病”(当时不清楚病因,故以此命名)的发生导致了AF(黄曲霉毒素)的发现。AF是一类结构和理化性质相似的真菌次级代谢物,是自然界中已经发现的理化性质最稳定的一类霉菌毒素。
黄曲霉素的毒性远远高于氰化物、砷化物和有机农药的毒性,其中以B1毒性最大。当人摄入量大时,可发生急性中毒,出现急性肝炎、出血性坏死、肝细胞脂肪变性和胆管增生。当微量持续摄人,可造成慢性中毒,生长障碍,引起纤维性病变,致使纤维组织增生。
广告位
点击排行
- 2 排行
- 3 排行
- 4 排行
- 5 排行
- 6 排行
- 7 排行
- 8 排行
- 9 排行
- 10 排行
热点追踪
广告位





















